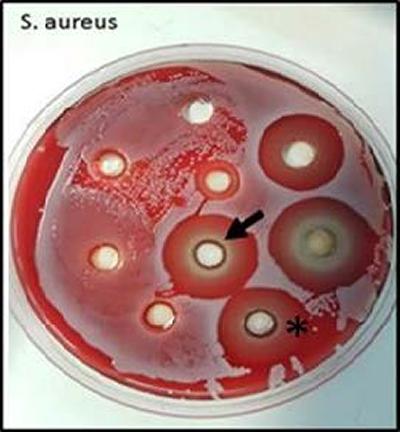
Culture plate showing inhibition of bacterial growth around clay gel

Dr Janos Kanczler, a Researcher within the Faculty of Medicine and a recipient of NAMRIP pump priming funds, presented this research at the Global-NAMRIP Festival of Early Career Research on 25 June 2019. The poster can be downloaded via the 'Useful Downloads' link below.

Infection is a leading proponent of orthopaedic implant failure. Enhancing the implant surface properties to initiate bone growth while simultaneously preventing microbial adhesion will be critical for clinical efficacy of implant surgery. The aim of this initial study was to produce proof-of-concept data on the potential of a nanoclay (Laponite) gel to deliver active antimicrobial agents.
Laponite gel (1&2wt%) with incorporated doses of chlorhexidine (CHX) (0.13%&1.3%) were placed into agar plates. Various bacterial strains E. faecalis, S. anginosus, S Aureus were cultured in the presence of the laponite gels overnight. Bacteria growth was measured by visual inhibition around the gel and by optical density scanning.
Release of CHX from the gel into the surrounding area was dependent upon laponite and CHX concentration. At 1%-Laponite+CHX-0.13% we demonstrated small inhibition zones of bacterial growth around the gels. This was further increased with 1%-Laponite+CHX-1.33% gels. Higher concentrations of the Laponite gel (2.5%) appeared to retain the CHX reducing the ability to inhibit microbial growth. However, no bacteria was detected on the gels itself.
The team demonstrated that a low concentration of laponite/CHX can repel the growth of bacteria in close proximity to the gel. Future testing with a compatible bacterial agent/laponite and dual release of osteogenic factors will determine the potential use for coating of orthopaedic implants for future dual osteogenic induction and anti-microbial reduction in joint replacement care.
The authors of this research are Kanczler J 1 , Li T, Dawson J 1 , Schneider P 2 , Sengers B 2 and Oreffo ROC 1
1 School of Medicine, University of Southampton and 2 School of Engineering, University of Southampton